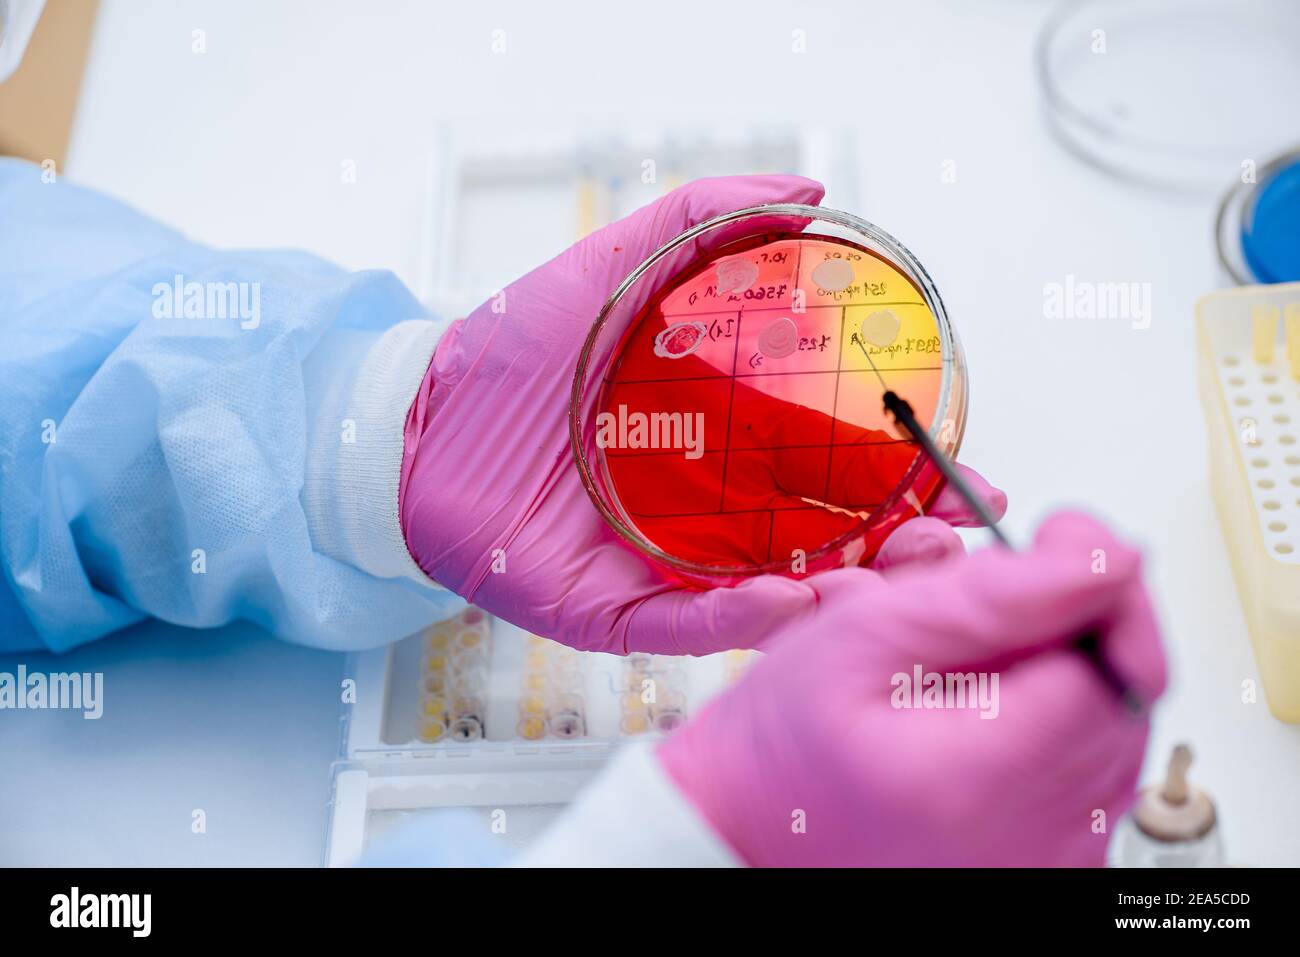
Primo piano della coltura di inoculazione batterica in una capsula di Petri. Analisi batterica di laboratorio Foto Stock
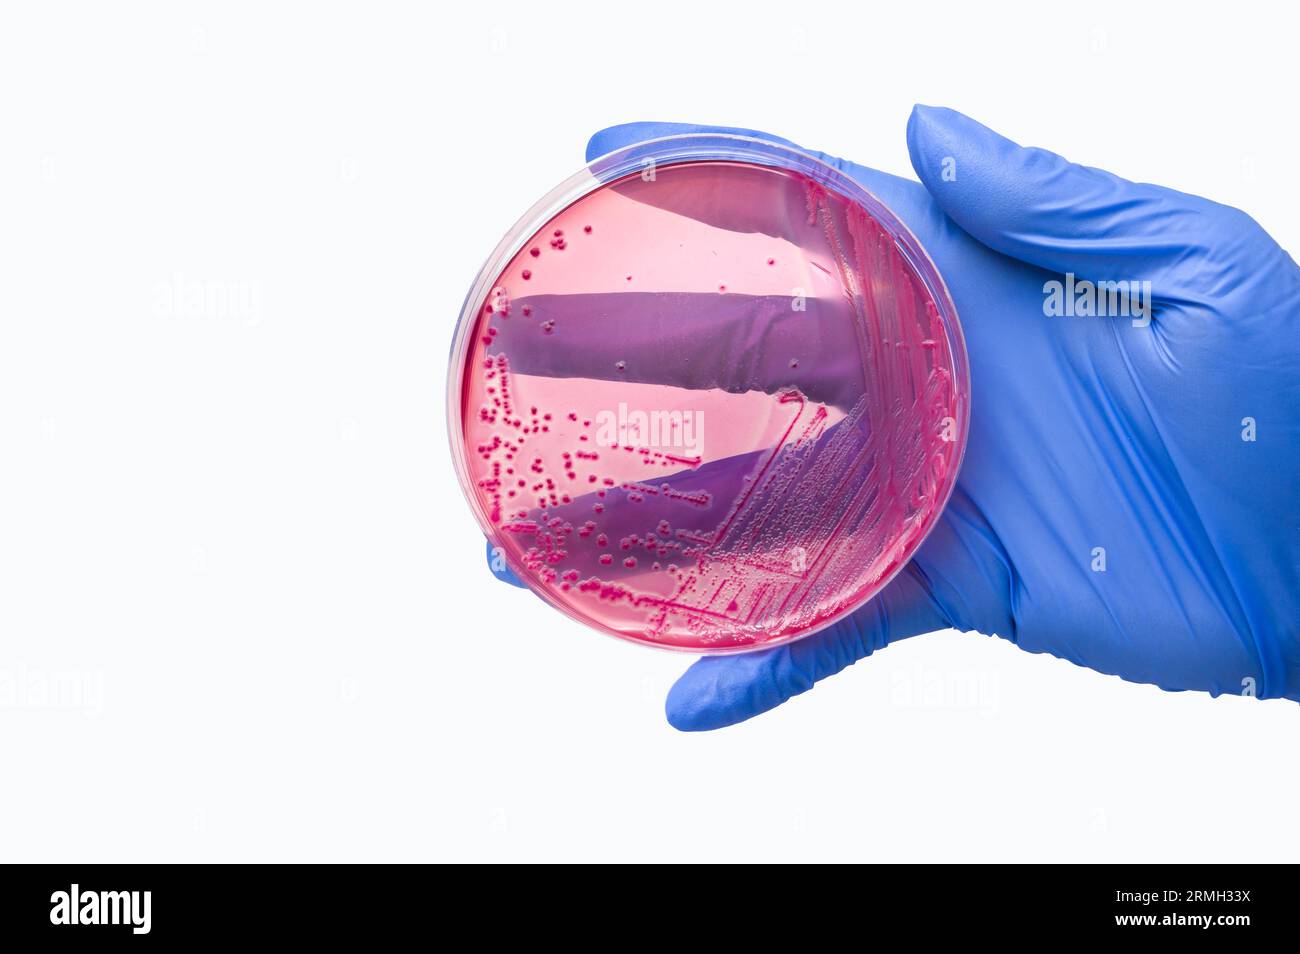
Le mani con guanto possono contenere la piastra Petri con colonie di Escherichia coli su agar MacConkey, inoculata con metod strisciante Foto Stock

Infezione intestinale Immagini Stock
(3,379)Filtri rapidi:
Infezione intestinale Immagini Stock

RMMF8C84–Nematodi parassiti o vermi rotondi, il contenuto dello stomaco di un pollack, Pollachius pollachius England Regno Unito.
RF2EA5CDD–Primo piano della coltura di inoculazione batterica in una capsula di Petri. Analisi batterica di laboratorio

RF2NERX98–Avon, Stati Uniti d'America - 17 giugno 2022: Primo piano di marca pinrid di oltre il farmaco contro il trattamento pinworm con etichetta segno in spagnolo

RF3DC58AE–Giovane montone muflon (Ovis gmelini) in aprile con problema metabolico visibile, infezione intestinale, Germania

RFHNG5PP–Tecnico di laboratorio prove per intestinale infezione batterica, mano trattiene il test campione nella scatola di Petri.colonie batteriche di crescita. Medical Hospital resea

RMG1567M–Micrografia luce del scolex (testa) di una tenia Dipylidium (sp). Il rostellum (in giallo) ha quattro file di ganci che, insieme con i quattro ventose (in blu), collegare l'scolex della tenia alla parete intestinale del suo ospite. Una infografica, con la

RF2RNAFJ7–Ascariasi - infezione parassitaria intestinale che può causare dolore addominale e malnutrizione.

RF2JEN653–Concetto di SIBO - piccola crescita batterica intestinale scrivere su note appiccicose isolate su tavola di legno.

RMKGD1GK–Grande palla di capelli da un giovane di gatti selvatici infestati con ascaris roundworms, un comune parassita intestinale worm. Il grande verme femmina nel centro era un

RF2YAKEA9–Avon, Stati Uniti d'America - 4 agosto 2022: Medicazione Pinworm medicazione Pinrid contro parassita umano worm rotaia, mano tenuta su sfondo bianco

RF2B6TEA2–COVID-19 Coronavirus 2019-nCoV Wuhan donna cinese con infezione da virus sintomi di malattia segni: Febbre, tosse, problemi gastrointestinali, polmonite. Intestazione banner panoramico malata con mal di testa.

RF2YE3N7C–Infiammazione intestinale. Sindrome dell'intestino irritabile. Uomo che tocca lo stomaco, soffre doloroso di mal di stomaco, sistema gastrointestinale desease causa di

RF2PH566D–L'uomo in piedi su uno sfondo scuro. Immagine di un sistema digestivo umano e intestino. Anatomia di intestino sano. Concetto medico, intestinale

RF2M78A7J–Infiammazione intestinale. Sindrome dell'intestino irritabile. L'uomo che tocca lo stomaco, soffrendo doloroso di stomachache, la causa di desease del sistema gastrointestinale di st

RF2M129NH–Intestino sano. Carino intestino cartone animato con gli occhi. Concetto di digestione intestinale sana, screening del cancro del colon, trattamento della malattia intestinale, biologia e.

RFW3CWTE–Caterpillar giocattolo con sorriso, per illustrare i concetti di infantile salute intestinale.

RMBWMTE8–Campione scientifico capsule contenenti un parassita Hookworm presso l' Università di Nottingham. Foto:Jeff Gilbert

RF2HE7NHR–Capsule Enterol di Biocdex. Medicinale antidiarroico contenente il lievito Saccharomyces boulardii.

RF2AEGJ5X–Rotavirus parola fatta di lettere rosse su sfondo blu. Il concetto di infezione da rotavirus in bambini e adulti, influenza intestinale, la medicazione

RF2HJM6JF–3D resa illustrazione medicalmente accurata dei villi intestinali con Corona Virus in un concetto di salute. Microbiologia, anatomia, biologia, scienza,

RF2G79XJE–KALININGRAD, RUSSIA - 03.07.2020 - Himalaya Bael ayurveda integratore alimentare per il movimento intestinale migliorando la flora intestinale e aiutando diges sani

RF2T4FMMT–HUETTENBERG, GERMANIA - 24 SETTEMBRE 2023: Box CANIKUR è un alimento dietetico appositamente sviluppato per il cane per regolare la funzione intestinale della diarrea

RF2T0FNN8–Dewormer per cani in mano davanti al cane sfocato. Prescrizione masticabile. Somministrare il trattamento per cani e cuccioli per vermi intestinali come il cuore

RMPMXG99–Vancomicina 125 mg. Oral antibiotico è un farmaco di prescrizione usato per trattare le infezioni da Clostridium difficile e staph.

RF2C8M214–Prebiotici per scrittura a mano con marcatore,. Concetto farmaceutico di medicina di sanità

RF2AR29WT–Iscrizione Rotavirus Infezione su sfondo tavolo di legno scuro. Concetto di assistenza sanitaria

RF2F4DYCT–Infermiere che tiene un tubo. Test del rotavirus. Uomo che indossa una maschera facciale che afferra un campione di feci da esaminare in laboratorio

RF3DXGY5W–Canale intestinale carnoso rivestito con germi all'interno, rendering 3d. Illustrazione 3D.

RFTA7M9R–Uomo vecchio con il grigio barba lunga ha problemi di stomaco. infezione, senior l uomo ha cibo nato malattia.intossicazione acuta s. close up vista laterale foto

RMA790NG–Micrografia elettronica a scansione di Escherichia coli cresciute in coltura e fatto aderire ad un vetrino

RME0BNA6–Un cetriolo come un simbolo per la malattia EHEC, Eine Gurke simbolo als fuer die EHEC Krankheit

RFPJGNEB–Giovane uomo con un forte dolore allo stomaco su sfondo blu. Il giovane uomo si aggrappa allo stomaco. Problemi digestivi. colite malattia intestinale

RF2AMEGXY–Cani vietati sul campo sportivo portatile plastica segno graminacee campo di cricket Parnell club di cricket, Parnell, Auckland, Nuova Zelanda.

RF2WYJF34–Rendering 3d di Giardia, è un parassita microscopico che vive nell'intestino. Il parassita può causare un'infezione intestinale chiamata Giardiasis

RF2KDKMYH–Illustrazione del tratto intestinale 3D. Vista anteriore o frontale dell'apparato digerente o dell'intestino umano. Infiammazione o infezione dello stomaco, anatomia

RFW6YDK2–Bacteries di intestino umano, della flora intestinale gut concetto di salute. 3d illustrazione

RF2STYD96–Batteri intestinali bianchi ( Salmonella ) isolati sul nero. Microbiota intestinale batterica e infezione

RF3A3NPE6–Appendicite. Morbo di Crohn. Infezione intestinale. Peritonite. Febbre tifoide. Colica renale. Salmonellosi. Gonfiore addominale. Infiammazione di grandi dimensioni

RFKFNNE4–Intestinale e intestino il dolore e la digestione gastrointestnal infiammazione problema come la digestione Malessere o stitichezza e infezione.

RF2PYMAEG–Parassiti nell'intestino. Indigestione, germi, infezione e virus nel corpo. Pareti intestinali e infiammazione virale al microscopio. 3D illustratio

RF3AE52AJ–Un uomo malato sul divano, che tocca la pancia in cattive condizioni soffre di mal di stomaco, malato, lotta con il dolore cattivo

RF2WDNAK0–Kiev, Ucraina - 24 ottobre 2023: Studio Shoot of Enterogermina pack and suspension Flasks Drug by Sanofi for treatment and Prevention of intestinal d
RMP24TAX–. Gli Ascaris vermicularis 23 Ascaris vermicularis - - Stampa - Iconographia Zoologica - Collezioni Speciali Università di Amsterdam - UBAINV0274 104 03 0023

RFMDP026–Antielmintico compresse pillole in blister su sfondo bianco con copia spazio. Industria farmaceutica concetto. Set di antielmintico compresse pillole :

RMK1FB80–Questo fotomicrografia raffigura il istopatologiche cytoarchitectural, modifiche che riflettono un'amebiasis intestinale infezione. Nota la forma morfologica di questo tipico pallone a forma di ulcera della mucosa intestinale. Immagine cortesia CDC/Dott. Mae Melvin, 1982.

RF3DHFT2K–Batteri Escherichia coli con flagella e struttura cellulare dettagliata in un ambiente microscopico blu. Illustrazione 3D.

RF2B832FM–Due pacchetti di pillole bianche su sfondo giallo personalizzato, concetto di farmaci e medicina.

RF3BDW37N–Fermare l'infezione da giardia lamblia, parassita barrato causando giardiasi, diarrea, e malattie intestinali, assistenza sanitaria e medica

RFT3CT95–Digital composito di evidenziati in blu intestino sano di donna / health care & medicine concetto

RF2GAF2DT–La parola probiotici e il sole è steso in compresse bianche su sfondo blu. Il concetto di medicina, intestino sano

RF2KG6B9T–parassita umano. malattia da infezione intestinale. infezione da microrganismi in ospedale nelle persone

RFM5KGG7–Microbiome : migliaia di microrganismi, batteri, virus, microbi strisciando , dibattere, riproducendo, moltiplicando , vive sul corpo umano.

RF2M540D9–Concetto medico. Su una superficie bianca, tavolette e puzzle con l'iscrizione - DISBIOSI INTESTINALE

RMCF211W–Helicobacter pylori INFAI kit di test diagnostico, che misura carbonio-13 esalata emissioni in respiro

RF2ADJD9P–Alcuni parassiti in recipienti di laboratorio su un tavolo in un laboratorio di microbiologia e alcune persone in camice bianco sullo sfondo

RF3DT9788–Immagine di una giovane donna con mestruazioni mal di stomaco dolore problemi di stringere lo stomaco. Malattia addominale del ventre nella persona femminile.

RF2SDXP8E–Vista ritagliata del giovane medico con un camice bianco che punta il dito verso l'alto sulle lettere "IBD". Concetto medico.
RF2RMH33X–Le mani con guanto possono contenere la piastra Petri con colonie di Escherichia coli su agar MacConkey, inoculata con metod strisciante









































